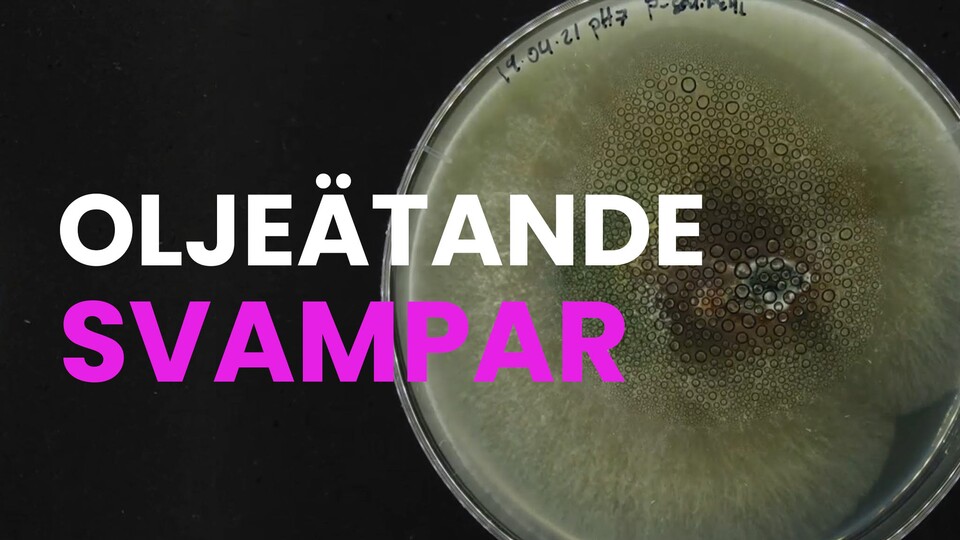

Oljeätande svampar
Om programmet
Forskarna har hittat ett sätt att använda svamp för att sanera en kraftigt förorenad gruva utanför Stockholm.
- Ämnesord:
- Biologisk rening, Botanik, Forskning, Föroreningsfrågor, Kryptogamer, Miljöfrågor, Naturvetenskap, Olja (petroleum), Svampar
- Produktionsår
- 2024
- Tillgänglig till
- 30 juni 2028
- Talat språk
- Svenska
- Undertexter
- Svenska
Dela programmet
Pedagogiskt syfte
- Utbildningsnivå:
- Allmänbildande
- Ämne:
- Biologi, Djur och natur
Vi har för närvarande inget arbetsmaterial för detta program.
Läs mer om hur vi arbetar med pedagogik och arbetsmaterial